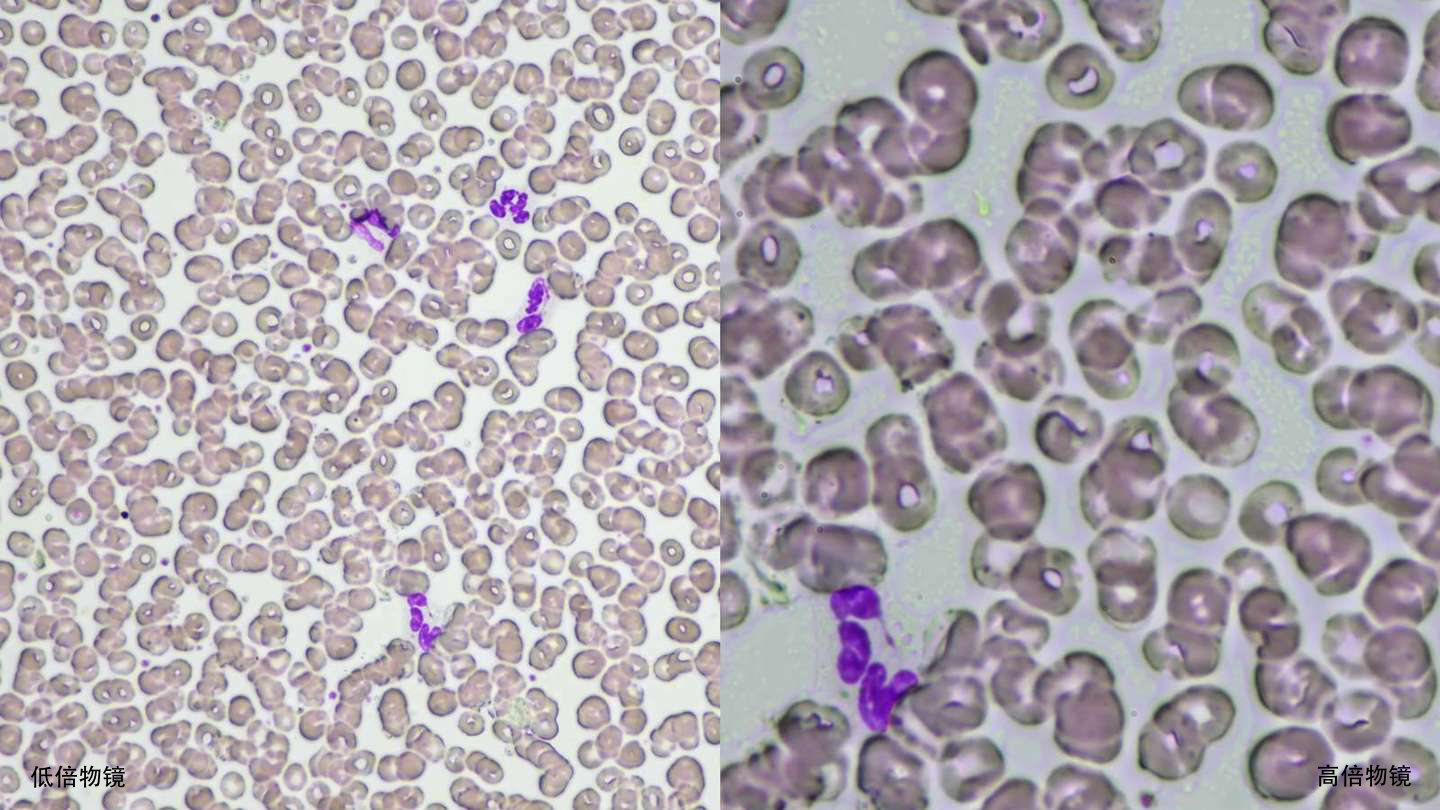
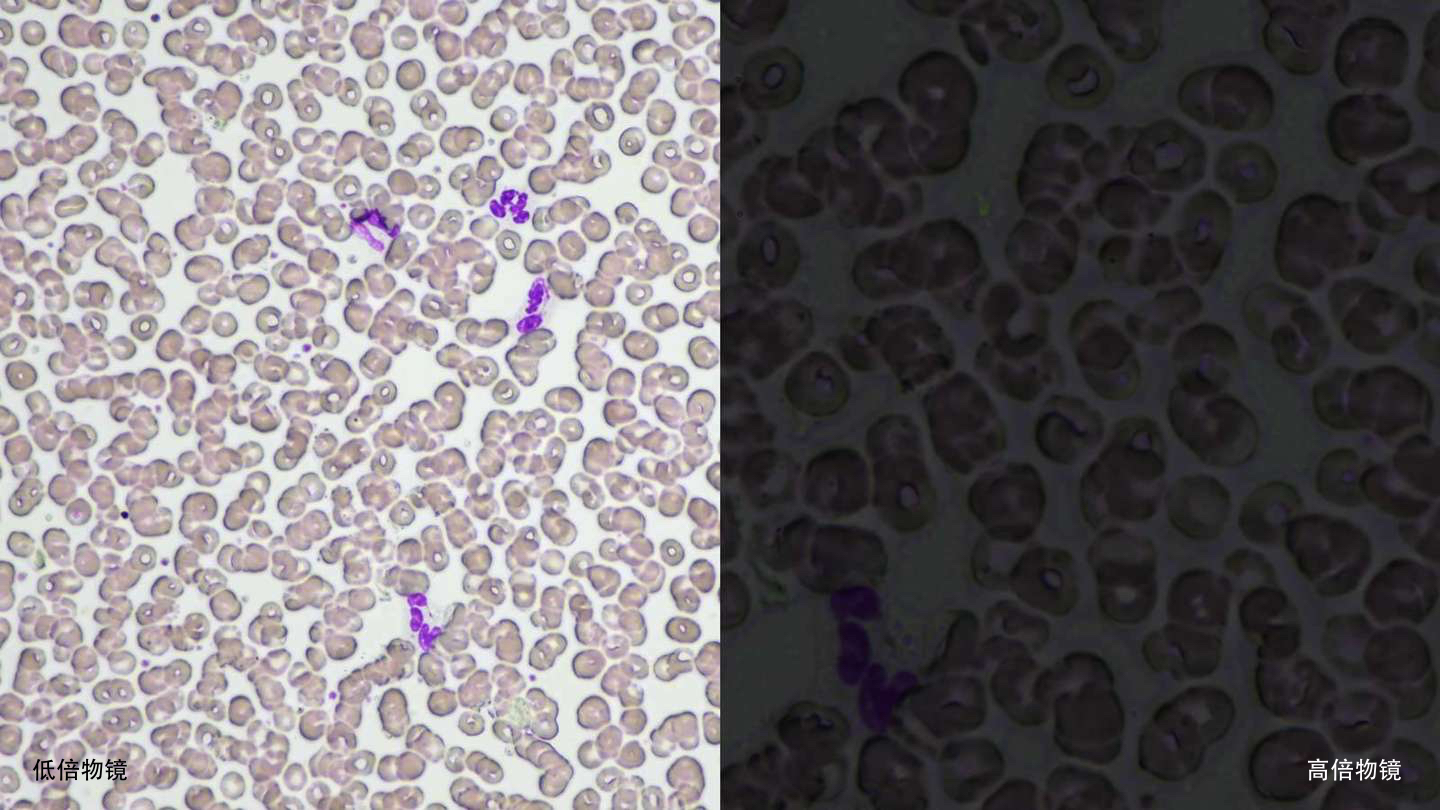

卓越人体工学设计,操作更舒适,给力每一天
很多情况下显微镜观察都必不可少。研究人员需要快速准确地完成任务,同时长时间保持专注。
生物显微镜“尼康ECLIPSE Ci-L plus”的设计在重视易用性的同时也注重了研究人员的健康和工作方式。
具有更高舒适度和可用性的Ci系列为显微镜观察带了革命性的改变。
Description
主要特性
即使长时间使用也不易引起眼睛疲劳
尼康开发的光强度管理 (LIM) 功能会自动存储亮度设置的任何变化。这有助于避免观察过程中在不同放大倍率之间切换时亮度发生剧烈变化,从而有助于减轻眼睛疲劳
有LIM功能
无LIM功能
观察时可保持自然姿态
通过自动亮度调节保持不变的观察姿态
LIM功能可保存并调出每个物镜的最佳亮度级别,无需在每次切换物镜时手动调整光源和改变姿态。


注重消除颈部,肩部及背部压力,符合人体工学的设计
可以倾斜和延长目镜筒,通过改变手柄的高度可以调节肘部的角度,让您能够始终保持舒适的姿态,从而减少身体的紧张疲劳。


用户友好的载物台操作
通过添加物镜转盘垫片,可将载物台高度从标准位置降低20 mm,从而减少频繁更换样品时的应变。载物台手柄高度也可以改变,以确保舒适的手部位置。可以使用重新调焦旋钮锁定载物台高度,以便在样本更换后快速重新对焦。载物台涂有高耐久性、耐刮擦的陶瓷涂层。


高度可调节的载物台手柄

陶瓷涂层的载物台
注意:上面显示的产品是不同的ECLIPSE Ci型号
在观察过程中体验更高效率的乐趣
一目了然的状态显示,便于轻松确认
无需改变观察姿态,使用显微镜底部的显示屏即可迅速轻松地确认放大倍率和亮度设置。


❶启用Eco模式
❷启用LIM
❸物镜
❹倍率
❺亮度设置
在转动物镜转盘时自动调节标尺
电脑显示屏上的标尺会自动更改以匹配放大倍率,无需手动设置标尺。

*单独出售:软件(NIS-Elements D / BR / AR),需要尼康所推荐的相机
明亮均匀的环保照明
Eco-illumination 是一种低功耗、环保的照明系统。其60,000小时的高亮度LED可以产生均匀的亮度,并降低灯泡更换的成本和工作量。通过组合准直透镜、复眼光学器件和LED照明,即使在高倍率下也可以获得明亮和边缘到边缘的均匀图像。LED照明器具有低发热量,并在每次放大时提供相同的色温。

轻松捕捉图像
在观察期间,只需单击显微镜底座上的图像捕获按钮,Digital Sight相机即可捕获标本图像。DS-L4相机控制单元触摸屏上的观察技术图标为每种观察方法提供了最佳的相机设置。此外,ECLIPSE Ci系列显微镜可通过DS-L4连接到远程PC,以实现远程查看,在线教育和远程协作。

图像拍摄按钮

DS-L4相机控制单元

通过网络的数字病理学
注意:上面显示的产品是不同的ECLIPSE Ci型号
多种观察技术
相差
无论放大范围如何,都可以捕获具有中性背景着色的高对比度图像。该观察技术适用于观察未染色的结构。


相差配件和物镜
简易偏光
非常适合观察双折射样品,如胶原蛋白、淀粉样蛋白和晶体。

2.8-二羟基腺嘌呤晶体,简易偏光,CFI Plan Fluor 40X
日本大学板桥医院临床实验室

简易偏光配件
*有两种类型的检偏器:中间镜筒型和物镜转盘滑片型。
灵敏的彩色偏光
通过改变干涉色来识别尿酸晶体。这种技术非常适合痛风和伪痛风测试。

尿酸钠晶体,灵敏的彩色偏光,CFI Plan Fluor 40X
日本大学板桥医院临床实验室

灵敏的彩色偏光配件
*有两种类型的检偏器:中间镜筒型和物镜转盘滑片型。
暗场
能够清晰观察血液或诸如鞭毛的微小结构。可提供干式和油式聚光镜。扩展镜头用于更明亮的成像。

落射荧光
采用噪声终止机制的紧凑型落射荧光附件可以以极高的清晰度和亮度拍摄弱荧光标本。CI-FL落射荧光附件(包含多达4个滤光片立方体)和D-FL落射荧光附件(最多可包含6个滤光片立方体)可轻松切换块。可提供用于落射荧光成像的高光学性能物镜,包括CFI Plan Apochromat Lambda系列和CFI Plan Fluor系列。


CI-FL落射荧光附件和滤光块
附件
满足多样化需求的物镜
我们提供各种最适合实验室及观察工作的物镜,例如工作距离可长达16mm的Plan Fluor 10X物镜,以及具有卓越光学性能的CFI Plan Apochromat Lambda系列物镜。

数码显微镜相机DS-Fi3
590万像素的CMOS图像传感器能够捕捉高达2880 x 2048像素的图像,其色调可以如实地表现样品。

NIS-Elements L成像软件
将Digital Sight 1000或DS-Fi3与安装了NIS-Elements L的平板电脑连接,就能通过网络与其他电脑共享被观察的标本图像。该软件还包含各种测量和注释功能。




